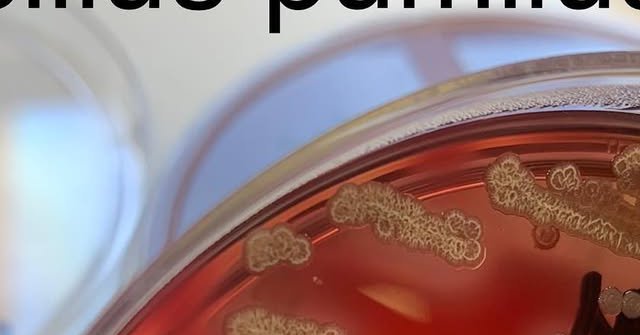
Tweet card summary image

jcolo
@jcolo67
Followers
2K
Following
2K
Media
607
Statuses
3K
👉 Según criterios PROA, ¿qué elegirías para una infección por Klebsiella pneumoniae productora de carbapenemasa tipo OXA-48?
0
0
0
‼️Esta semana, hemos presentado formalmente la solicitud de creación de la especialidad MIR de #EnfermedadesInfecciosas. En este sentido, se ha informado de esta decisión en persona a @sanidadgob y @Evelascomorillo, como portavoz de #Sanidad del partido líder de la oposición, y
6
47
98
📢 ¡Publicado el nuevo Plan Nacional Frente a la Resistencia a los Antibióticos 2025-2027! Un enfoque multisectorial para proteger la salud humana, animal y el medio ambiente. 💪🌍 🆓 https://t.co/bSprBZpwp8
#SaludPública #OneHealth #ResistenciaAntimicrobiana
0
24
47
🆕Propuesta de "ampliar" las categorías de las infecciones del tracto urinario: ITU, bacteriuria asintomática (BA), no ITU, y dos nuevas... · BA de significado incierto (BSI) y · Síntomas urológicos sin bacteriuria (SUSB) 👇 https://t.co/Fi2BJioehz
0
17
30
#Noticia | 🗣 Dra. Matilde Sánchez: "Sin un título reconocido (en enfermedades infecciosas) como tal en España, no podemos ir fuera a trabajar como infectólogos” #SíEspecialidadEI #SpainhasnoIDspeciality La presidenta del #XXVIIICongresoSEIMC analiza para @Elmedicoint las
0
12
14
¡INTERESANTE! 📚 Guía sobre cómo usar #ChatGPT en publicaciones científicas: ✍️ Título 📝 Resumen 📖 Introducción 🔬 Metodología 📊 Resultados 💬 Discusión ✅ Conclusiones 📚 Referencias 🔗 https://t.co/zu21cvalgw
2
137
507
20 intoxicados por una grave bacteria tras comer en el evento ‘The Champions Burger’ en Pamplona | #EcoliO157
elpais.com
Más de 150.000 personas acudieron en la capital navarra al concurso, que recorre toda la geografía española en busca de “la mejor hamburguesa del país”
6
12
34
¡NOVEDADES en diagnóstico d ITU!: 📸Indicativos= disuria + frecuencia + urgencia urinaria 📸Eliminar "ITU complicada" x "ITU cn afectación sistémica" 📸Piuria "significativa"= >200/microL 📸Recomendar urinocultivo (incluso en AP) 📸Bacteriuria= 10^4 UFC/ml (o 10^3 si E.coli)
0
93
270
¡En el Día Internacional de la Sepsis, rendimos un homenaje a nuestros compañeros los microbiólogos! 💙🔬 🥷Invisibles pero trabajando en el laboratorio para detectar, identificar y tratar precozmente a los microorganismos responsables de esta enfermedad. https://t.co/RIMG5Kc0q7
0
26
74
🔎La OMS presenta su Agenda Global de Investigación para combatir la resistencia a los antimicrobianos (#RAM). Describe 4⃣0⃣ temas de investigación esenciales para abordar la resistencia en bacterias, hongos y tuberculosis para 2030. https://t.co/Psw3kBTXhz
who.int
WHO has published its first global research agenda for the world’s scientists to address the most urgent human health priorities to combat antimicrobial resistance (AMR).
0
6
30
Aumento de casos de sepsis neonatal grave en Francia por virus ECHO-11. Entre julio-22 y abril-23, se reportaron 9 casos en 4 hospitales de 3 regiones diferentes. 7 niños fallecidos y 2 hospitalizados. OMS califica riesgo general como bajo. https://t.co/zrvgkzHox8
0
5
12
⚠️ Antibióticos, ¡tómatelos en serio! #ResistenciaAntibióticos
¿Utilizas correctamente los antibióticos? 🚫Los antibióticos NO curan infecciones provocadas por virus como el resfriado o la gripe‼️ ⚠️ Antibióticos, ¡tómatelos en serio! https://t.co/aCbegg0kEW
#ResistenciaAntibióticos
0
12
25
ESTO ES MUY GORDO...🫢🫢🫢 Impacto de la nueva interpretación de puntos de corte del Comité EUCAST, donde la mayoría de medicamentos antipseudomonas, excepto el meropenem, ahora se clasifican como "Sensible, mayor exposición" y se etiquetan como Intermedio...
5
55
137
👧7 años, desde los 4 años, episodios de odinofagia y fiebre de 4-5 días repetidos cada 30-45 días, sin cultivo + de estreptococo ni respuesta a los antibióticos: exudado en amígdalas, aftas bucales (fig.) y adenopatías cervicales. 1/7 #pediatria #medicine #MedEd
28
580
3K
La #poliomielitis parecía erradicada, pero los niños del mundo siguen en peligro si no se frena en Pakistán y Afganistán https://t.co/JGx3D3WkPz vía @el_pais
elpais.com
El virus de la polio vuelve a circular por Occidente y preocupa a las autoridades sanitarias. La enfermedad, altamente infecciosa, paralizante y, en ocasiones, mortal, se puede evitar con una vacuna
0
12
9
OPINIÓN | La urgente necesidad de la #especialidad de #infecciosas para asegurar el relevo generacional, por el Dr. José María Miró Meda, Consultor Sénior de Enfermedades Infecciosas del Hospital Clínico de Barcelona #SIEspecialidadEI
https://t.co/PPyv8tkJ8c a @eldiarioes
eldiario.es
Los actuales especialistas de enfermedades infecciosas y microbiología, son profesionales clave, junto con farmacéuticos y especialistas en medicina preventiva
0
34
59
Esto ya es una urgencia Sra ministra @CarolinaDarias @sanidadgob . Que no haya especialidad de E Infecciosas en España, no es solo vergonzoso. Es peligroso para los ciudadanos. @SEIMC_ @SAEI_tweets @ESCMID @IDSAInfo
@eldiarioes
https://t.co/TovkTaVEUd
eldiario.es
Los actuales especialistas de enfermedades infecciosas y microbiología, son profesionales clave, junto con farmacéuticos y especialistas en medicina preventiva
2
20
42
#RetoDelMes Tincion de Gram de una muestra de esputo de un paciente diagnosticado de fibrosis quística (FQ). Se observan bacilos Gram-negativos rodeados de una capa mucosa...¿que sospecharías?
6
28
105